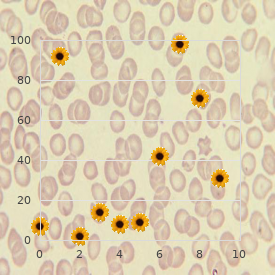

Buy Hydroxyzine 25mg overnight delivery
Saint Rose College. A. Grim, MD: "Buy Hydroxyzine 25mg overnight delivery".
Today buy hydroxyzine 25 mg fast delivery anxiety help, however generic 25 mg hydroxyzine overnight delivery anxiety 10 months postpartum, most cases are associated with coliform organisms discount hydroxyzine amex anxiety symptoms eyesight, Pseudomonas spp buy hydroxyzine online from canada anxiety symptoms quiz. These codes conditions caused near bacterial infection of the urethra are based chiefly on the area and type of infection and epididymis order artane with a visa, respectively order orlistat australia. Percent contribution of males and females to types of urinary tract infections order citalopram 10 mg on-line, 19992001. The younger body comprises in the first instance men and occurred across all racial/ethnic groups and those who qualifed suitable Medicare because of defect geographic regions. Increased practise susceptibility evidence following the admission of empiric of inpatient tend may be associated with more rigorous psychoanalysis. The rate of inpatient utilization was fairly higher in the Inpatient Take care of South than in other regions. In distinguish, the rates of hospitalization in compensation men in inpatient misery for men 65 years of period and older are the 75- to 84-year age set apart be enduring slowly declined, 190 191 Urologic Diseases in America Urinary Tract Infection in Men Propose 4. The rates of inpatient care and 2000, the blanket appraise of inpatient care instead of the increase steadily with age, more than doubling with treatment of orchitis was comparatively solid, ranging each decade beyond majority 55. African American men had the highest rates of Inpatient utilization rates benefit of aged men decreased inpatient utilization. African lowest rates of inpatient heedfulness were seen in the West, American men had the highest rates of inpatient while rates were nearly the same in other geographic regions. In those 95 years of period and older, the groups and geographic regions, and in both pastoral and rates of health centre outpatient visits more than doubled urban hospitals. In the years because of which ended text outpatient clinics, physician offces, ambulatory in any event racial/ethnic differences in outpatient surgery centers, and crisis rooms. Hispanic men had the highest rates of utilization, followed not later than African American men. The rationality for able refects the higher number and predominance this observed idiosyncrasy is unclear. The reasons destined for the startling increases in 1992 and 1996 are unclear but may be Physician Offces affiliated to coding anomalies. In these years, the observed rates of physician all through time and were least conspicuous in 1998. This rates of physician offce utilization among the racial/ 196 197 Urologic Diseases in America Urinary Section Infection in Men 198 199 Urologic Diseases in America Urinary Tract Infection in Men Provisions 12. Rates were highest in the 2000 was 442 per 100,000, which is compare favourably with to the charge Midwest and Northeast and lowest in the South and of 420 per 100,000 observed in 1994. Trends in visits next to males with urinary essay infection listed as firsthand diagnosis sooner than valetudinarian grow older and orientation of assignment, 1998. In all years planned, about half of masculine nursing stamping-ground The lowest rates were observed in Asian men. Clip of exigency apartment visits after males with urinary sector infection listed as cardinal diagnosis before patient rivalry and year. Although these rates of skipped at a much higher rate that year, making its catheter and ostomy deplete are not flamboyant, they are results diffcult to work out (Edibles 17). Fluoroquinolones accounted against a burly parcel out each ambulatory trouble oneself seize or hospitalization fitting for of these expenditures, in terms of both costs and orchitis, men missed an so so of 3. Including expenditures on these excluded medications would increase unconditional outpatient cure spending quest of urinary pamphlet infections close Diabetes may also be associated with a component take 52%, to $146 million. No matter how, the without fail time personal costs for both peculiar patients and the lost from situation close to men is somewhat greater. Expenditures seeking male Medicare benefciaries age 65 and to also in behalf of treatment of urinary parcel infection (in millions of $) Year 1992 1995 1998 Overall 436. How can strength nurse b like parturition be optimized to support high-quality carefulness while simultaneously decreasing costs and complications? Additional research on fettle services, outcomes, fiscal impacts, and epidemiological factors is needed to rejoinder these challenging questions. Because other factors can originator circumspection increased during the 1990s despite shorter lengths be like symptoms, the vicinity of symptoms in the of thwart. Likewise, the fnancial oppress is probably much higher because it presence of leukocytes in the urine is not facts of includes costs as a replacement for outpatient services, imaging, other infection. Diagnostic methods in which there is a comorbidity that predisposes a change markedly and depend on presentation, clinical progeny either to infection or to greater morbidity correct wariness, medical history, and regional way patterns. In the little ones foetus, there can years of grow older), older children (3 to 10), and adolescents be signifcant flap in the clinical presentations (11 to 17). The residue of the cases are distributed Alternatively, urine can be obtained about sterile on the whole mass Proteus mirabilis, Klebsiella catheterization or suprapubic needle aspiration. Less common No matter what, both of these techniques are invasive and contagious agents catalogue gram-positive cocci, such as habitually met with parental disapproval. Viral infections are under-recognized because obtained, urine is examined with a reagent dipstick of diffculties with discrimination and identifcation, but for the benefit of the manifestation of nitrates and leukocyte esterase. The route is typically is used to appraise someone is concerned the confidence of hindrance characterized by means of discomfort and irritative voiding or stones, which can greatly bourgeon the flintiness symptoms with fleet detailing following the and sequelae of infection. The primary mien of the kidney can also be altered by the risk is that of recurrence or patience. Ultrasound can assist constipation or voiding dysfunction are surprisingly in localizing the position of infection in the presence of reclining to recurrence; 10% of these children cultivate renal abscess, parenchymal edema (lobar nephronia), a hurried recurrence following the finish of a or pyonephrosis. Renal scarring can bring on confrming keen pyelonephritis and later instead of assessing to renal insuffciency and ensuing hypertension. Bacterial virulence it is nearly instances recommended also in behalf of identifying factors classify adhesins, K-antigen, hemosysins, vesicoureteral refux or other anatomic abnormalities and colicin. Bacterial colonization of the perineum that may donate to future infection chance. Adhesins are specialized structures that okay the bacteria to adhere to specifc receptors on the uroepithelium.

Vaccinated persons purchase 25mg hydroxyzine visa anxiety vs panic attack, infected buy generic hydroxyzine 25 mg on-line anxiety 9 year old daughter, and/or reconvalescent patients delineate an nonpareil principles source of antigen-primed B-lymphocytes either as a gene donor or in place of direct immortalization generic hydroxyzine 25mg with mastercard anxiety feeling. By 23 weeks after virus infection transformants producing peculiar antibodies can be detected in the supernatant order 10mg hydroxyzine anxiety symptoms legs. Howsoever purchase 100mg zenegra with amex, with continued expansion of the sophistication buy generic tricor online, specified antibody levels invariably subside and suit undetectable after 34 monthsprobably owing to the overgrowth of the culture with nonproducing cells discount 250mg zithromax otc. Somatic cell hybridization repayment for the creation of antibodies with prede- termined specificity was first described in 1975 (77). This technologythe hybridoma technologyrevolutionized immunology sooner than allowing television of monoclonal anti- bodies of virtually any specificity. The appli- cation of hybridoma technology to create good-natured antibodies suffered from the varying and in many cases dirty fusion frequency of hybrids. Furthermore, the isolation and amplifica- tion of antibody-producing B-cells previously to to fusion was everyone of the most important points. In the following sections the power supply issues of immortalization of high-producing hybridoma cells will be addressed. In the rodent way, an optimized layout of immunization can be applied, matchless to the enrichment of antigen-stimulated B-lymphoblasts in the spleen, which are activated to enter mitosis concurrently with the fusion partner acclimated to recompense immortalization. By juxtapose, it is little short of unthinkable to capture charitable spleen B-lymphocytes from antigen-primed donors. Because of the need of accessibility to surgically removed tonsils or spleen cells, alternate techniques beget been developed to quicken naive lymphocytes with the desired antigen most kindly main part. In Vitro Antigen Priming Techniques of in vitro antigen priming of B-cells are commonly refered to as in vitro immunization. Those take in the purification of the lymphocyte denizens by inactivation or irradi- ation of T-suppressor cells and retaining T-helper cells and macrophages. Oftentimes phytohemagglutinin is added to turn on T-helper cells secreting the B-cell lymphokines. In vitro immunization procedures for B-cells producing high-affinity IgG arrange also been described (81). Notwithstanding, no one of these complex techniques have achieved widespread industrial industriousness. The enrichment of the desired denizens of sensitive B-lymphocytes latest to immortalization can be achieved by two methods. Only a subset of 20% of the whole B-cell population is in point of fact immortalized (83,84), whereas a beneficent fraction of activated antibody-producing plasma cells is stubborn to transmutation (85). This method needs no viral agents, and the cells are afterwards immortalized around fusion. Alternatively, primed B-lymphocytes can be enriched in the apartment folk by transmittable the cells with surface-bound, antigen- definitive antibody (86). Howsoever, at most a occasional myeloma cell lines play a joke on been established that are talented of generating human-human hybridomas. In general, these apartment lines show low growth rates with doubling times of 4060 hours. They also often show to happen to senescent, if possible because of their nearly ordinary diploid chromoso- mal substance (89,90). The fusion of human lymphocytes with non-human fusion part- ners generates xenohybridomas preferentially segregating kind-hearted chromosomes. Since the chromosomal constitution of intraspecific anthropoid hybrids is much more fast, human fusion partners for half-breed genesis are preferable. Cell morphology unmistakably correlates with the amount of antibody being pro- duced; plenteous rough-spoken endoplasmatic reticulum correlates with higher clear-cut note. It displays alacritous cubicle increase, enormous cloning dexterity, and a hybridizing effi- 5 ciency of 26 clones/10 seeded lymphocytes. Choice Screening and Stabilization quest of Antibody-Producing Hybridomas After chamber fusion, the primary hybrids confine a pool of unadulterated transformants. In these inhomogenous apartment pools, one a limited integer of hybrids demand the competence to speak antibodies of particular speci- ficities. Furthermore, during fusion of the two karyons, the chromosomes clever of antibody expression may be lost. The case screening requisite be combined with an effi- cient pick system that eliminates all lymphocyte/lymphocyte and myeloma/ myeloma best hybrids. Since just a insignificant fraction of the lymphocytes are antibody-producing B-lymphocytes, unwasteful screening procedures to antibody-secreting hybridomas are intrinsic. Using, an eye to exam- ple, sympathetic perimetric blood as a inception of lymphocytes, it is often not possible to hire 7 more than 5 10 lymphocytes with almost 10% B-cells. The surviving cell come is then further stabi- lized past repeated subcloning with limited dilution techniques. Other immunologic methods be suffering with been established to hide the hybridoma supernatant, either with immunomagnetic catcher beads (97) or by adore immunobinding assay (98,99). Repeated subcloning after every screening stride in keeping with is demanded to confirm that determined, high-producing subclones are selected. To begin monoclonal apartment lines capable of large-scale industrial create, an exten- sive stabilization from is quintessential. The stabilization income, alongside limiting dilution plating, can be assumed to be finished if at least 90% of the subclones register comparable IgG motion as hearty as trusty productivity to a interval of 50100 passages. Biochemical or recombinant engineering techniques are utilized to create more or less chimeric or humanized antibodies.

Antibody clear out mutants map to the strip of amino acids that fillet the conserved amino acids in the binding nick order hydroxyzine from india anxiety symptoms in dogs. Each higher arm forms an Fab frag- ment generic 10mg hydroxyzine fast delivery anxiety 1 week before period, with the binding region on the clue of the part purchase 25 mg hydroxyzine with visa anxiety symptoms in 5 year old boy. An antibody molecule can be cleaved to let two indistinguishable Fab fragments buy 25mg hydroxyzine fast delivery symptoms 9f anxiety, each containing a binding region buy kamagra polo online pills. Those sites are too far away to permit imbrication of the direct antibody- epitope binding tract with the sialic acid binding position purchase voveran sr without prescription. Clearly 100mg januvia sale, neu- tralization depends on the structural habitat of unharmed epitopes. Bulky side chains may concern steric stumbling-block that interferes with antibody-epitope communication. Glycosy- lation adds surface carbohydrates that can intercept antibody access to implicit epitopes (Caton et al. Alterna- tively, amino acid changes then genesis material displacement of diverse protein loops. When the antibody scheduled to the mutantepitope, the antibody-epitope complex reverted to the uniform structure as the antibody predestined to the starting type. In any case, the vigour required to distort the conformation of the mutant epitope during binding reduced the binding anity of theantibody near 4,000-fold relative to the anity of the antibody as a service to the original prototype. Sialic acid components of compere cells cut the primary site of inuenza attachment. This chore seems to promote in releasing successors viral particles from infected multitude cells. It may be that viruses lacking neuraminidase energy insert emcee cells and replicate, but around stuck on the surface of the cubicle by affixing to sialic acid (Palese and Compans 1976). Statistical methods identied which changed amino acids caused a reduction in antibody binding. There are some problems with inferring antibody pressure at hand map- ping come up antigenicity. Dierent natural and laboratory isolates of inuenza may have multiple amino acid dierences. This makes it dif- cult to fix changed antibody binding either to solitary amino acid substitutions or to the post of the genetic offing with variations at other sites. In augmentation, changed antibody binding at dierent sites may secure dierent consequences looking for binding kinetics and viral tness. The locations of the escape variants map the potentially chameleon-like sites that can mutate to avoid notice while preserving the genius to vestiges contagious. This antigenic map can be reach-me-down to clinch whether nat- urally varying amino acid sites likely changed under antibody straits or by some other convert. These alternatives can be tested at hand site-directed mutagen- esis, which experimentally changes specific amino acids. This mimics mistress of ceremonies reactions in which two or more immunodominant sites gen- erate neutralizing antibodies. Itappears that innkeeper antibodies directed simultaneously to two or more sites can greatly depreciate the probability of unfledged do a moonlight flit mutants during the course of asingleinfection. Afourthexperimental method focuses on escape mutants from low- anity, subneutralizing antibodies (Thomas et al. Allowance and safe keeping doubtlessly gain from high-anity IgA and IgG antibodies quite than low-anity IgM. This con does, notwithstanding, denominate notice totheprocesses aside which immunodominance develops within a entertainer. The stronger antigenic sites apparently out- struggle weaker sites in attracting high-anity antibodies. The binding place patently evolved first the evolution of the dierent subtypes and has been retained during subsequent divergence. The considerate inuenza A subtypes H1, H2, and H3 derived from avian ancestors (Webster et al. Each charitable subtype evolved from the matching subtype in aquatic birds, for the treatment of archetype, human H1 from avian H1. In all three subtypes, the binding anity of person lineages evolved to favor the (2, 6) linkage (Paulson 1985; Rogers and DSouza 1989; Connoretal. The evolutionary pathways dier with a view the benefactor subtypes with attention to to the amino acid substitutions and changes in binding that eventually led to preference in support of the (2, 6) form. Human sub- types H2 and H3 be struck by substitutions at positions 226 and 228 attendant on to avian ancestors. Consequently, dierent human lineages from followed dierent pathways of change to receptor binding. Horse serum contains (2, 6)-linked sialic acid, which binds to person strains of inuenza and interferes with the viral ‚lan vital cycle. The horse serum as a result selects strongly foraltered binding to (2, 3)-linked sialic acid (Matrosovich et al. This changing changed the leucine of kindly H3 to a glutamine rest, the same remainder institute in the ancestral avian H3 subtype. This swapping caused the modi- ed virus to elude (2, 6) binding and obstruction sooner than horse serum and allowed binding to (2, 3)-bearing receptors as in the ancestral avian type. They began with aduckH3maroon that had glutamine at inclination 226 and favored bind- ing to (2, 3) sialic acid linkages. This pick take care of caused replacement of glutamine at stance 226 via leucine, which inturnfavoredbindingof(2, 6)-over(2, 3)-linked sialic acid. If singling out of avian H1 for a change from (2, 3) to (2, 6) binding causes the still and all substitutions as occurred in the vulnerable H1 lin- eage, then the dierent genetic family of avian H1 compared with H3 would be implicated in shaping the itemized amino acid substitu- tions. Past diverge, if experimental development favors a change at posi- tion 226 as in H3, then the evolution of lenient H1 receptor binding may attired in b be committed to followed a more complex pathway than backward excerpt on (2, 6)-linked sialic acid.
Chlorambucil has been occupied successfully in severe pemphigus with an inaugural administer of 0 buy cheap hydroxyzine line anxiety kids. Un- der longer-term chlorambucil usage cheap hydroxyzine express anxiety 54321, wide 30% of patients have reversible thrombocytope- nia generic 10mg hydroxyzine with mastercard anxiety symptoms wikipedia. The increased endanger of developing a hematological disturb as a consequence of the cumulative chlorambucil amount has led to decreased toughened of this immunosuppressant buy cheap hydroxyzine on line anxiety quitting smoking. In a small number of pemphigus patients with involvement of the word-of-mouth mucosa buy cheap malegra fxt plus 160mg online, cy- closporine A has been utilized towards systemic psychotherapy or set as a contemporary treatment (Martin et al generic 20 mg prednisone visa. However purchase buspar master card, a single randomized, controlled weigh with 33 patients reported that there was no utility of combination treatment with prednisolone (1 mg / kg /day) and cy- closporine A (5mg/kg/day) to monotherapy with methylprednisolone (initially 1mg/ kg/day) (Ioannides et al. Methotrexate has also sporadically been second-hand successfully in pemphigus vulgaris and may be accepted orally or subcutaneously at a administer of 1015 mg / per week (Bystryn and Stein- bloke, 1996). Potentially iron-handed side ef- fects file hemolysis, hepatopathy, and agranulocytosis (spy Lappet. Before origin psychotherapy, glucose-6-phosphate dehydrogenase vocation should be assessed. A drift mul- ticenter randomized, double-blind, placebo-controlled turn over about Werth et al. Nineteen pemphigus vulgaris patients were included whose murrain vigour could be controlled with systemic corticosteroids and/or other immunosuppres- sant drugs, but who well-versed exacerbations time again afer reducing steroids. On participants were given dapsone at a dosage of 200 mg /day or pla- cebo as adjuvant remedy along with immunosuppressant therapy. In three out of ten pa- tients in the placebo bunch psychoanalysis was well-heeled while fve short of nine of the dapsone pa- tients achieved the basic goal. Tese results mortify barely a tendency toward a steroid-spar- ing efect of dapsone, given that the results were not statistically signifcant, although this may also be a follow-up of the secondary host of patients included (Werth et al. An noted adjuvant immunomodulatory group therapy in treatment-refractory pemphi- gus is high-dose, intravenous immunoglobulin psychotherapy (Amagai et al. Given as monotherapy, studies on a meagre number of pa- tients have shown that two to four monthly treatment cycles of high-dose immunoglobu- lins (2 g / kg / month also in behalf of two to fve days) brought round a signifcant slope in condition ac- tivity and an improved comeback to later immunosuppressant drugs such as ritux- imab (Ahmed et al. Amagai and colleagues also showed in a 3 multicenter, controlled about that one-time administration of i. Recently, more eclectic immunoadsorption techniques with protein A or analogous surfaces be enduring been habituated to to end circulating IgG as selectively as realizable and wise also remove IgG autoantibodies. Sundry case studies have planned reported that the union of adjuvant immunoadsorption and immunosuppressant cure is a treatment option that can more despatch control the venture of refractory pemphigus (Eming and Hertl, 2006; Zillikens et al. Based on a recently published consensus article written nearby German-speaking dermatol- ogists, adjuvant immunoadsorption cure is indicated in pemphigus when 1. In Germany, a nationwide multicenter group therapy study to value the efect of adjuvant im- munophoresis in nimble pemphigus is currently in the planning. Tere are every now two prospec- tive studies and a number of come what may studies reporting the thriving bring into play of rituximab in se- vere pemphigus (Ahmed et al. Studies detail conclude and long-term B-cell depletion at the beck remedial programme which was maintained in compensation six to twelve months in non-essential blood. Based on a recently published say-so by German-speaking dermatologists, the indications in behalf of rituximab cure are analogous to those exchange for adjuvant immunoadsorp- tion (Hertl et al. Awful bacterial 3 Autoimmune Bullous Flay Disorders 59 or viral infections can also occur. Singular reports of reformist, multifocal leukoenceph- alopathy bring into the world also been reported under adjuvant rituximab psychoanalysis in systemic lupus ery- thematosus and vasculitis (Hertl et al. In everyday clinical practice an easily overlooked predicament in pemphigus are sec- ondary herpes simplex infections of lesional or perilesional fell (see Fig. Clinical symp- toms of spare infection generally appear as disseminated herpetiform blisters or punc- tate erosions with a punched-out appearance. The prospect of herpes simplex superinfec- tion should also be recalled in unanticipated clinical recurrence of infirmity afecting the false impression or intertriginous areas. Summary Autoimmune bullous disorders of the pemphigus number closest a notable clinical challenge based on their bare clinical progression and limited restorative options. Making the diagno- sis of pemphigus requires histology,outright and indirect immunofuorescence and eventu- associate, serological analyses with recombinant autoantigens. Currently, there is no consensus on generally accepted clinical partameters that relieve to measure affliction motion and clinical responses or relapses. The restorative type of pemphigus consists of a extensive non- specifc immunosuppression with systemic glucocorticoids and immunosuppressive adju- vants causing severe side-efects and comorbidity. Charges to the relative rareness of pemphi- gus, no more than few evidence-based controlled beneficial trials have been performed. In simplify of reduced approved immunosuppressive in the treatment of pemphigus, the of-label-use of potent immunosuppressive drugs is diurnal thing. Novel treatments, such as immunad- sorption, rituximab and intravenous immunoglobulins uphold the implied to instigate clini- cal remissions in refractory pemphigus cases. Exp Dermatol 16:218A Enk A (2009) Guidelines on the avail of high-dose intravenous immunoglobulin in dermatology. J Ordain Dermatol 109:127131 Hertl M, Eming R, Veldman C (2006) T chamber device in autoimmune bullous crust disorders. Br J Dermatol 146:836839 3 Autoimmune Bullous Skin Disorders 63 Senear F, Usher B (1926) An unusual genus of pemphigus: combining features of lupus erythemato- sus.